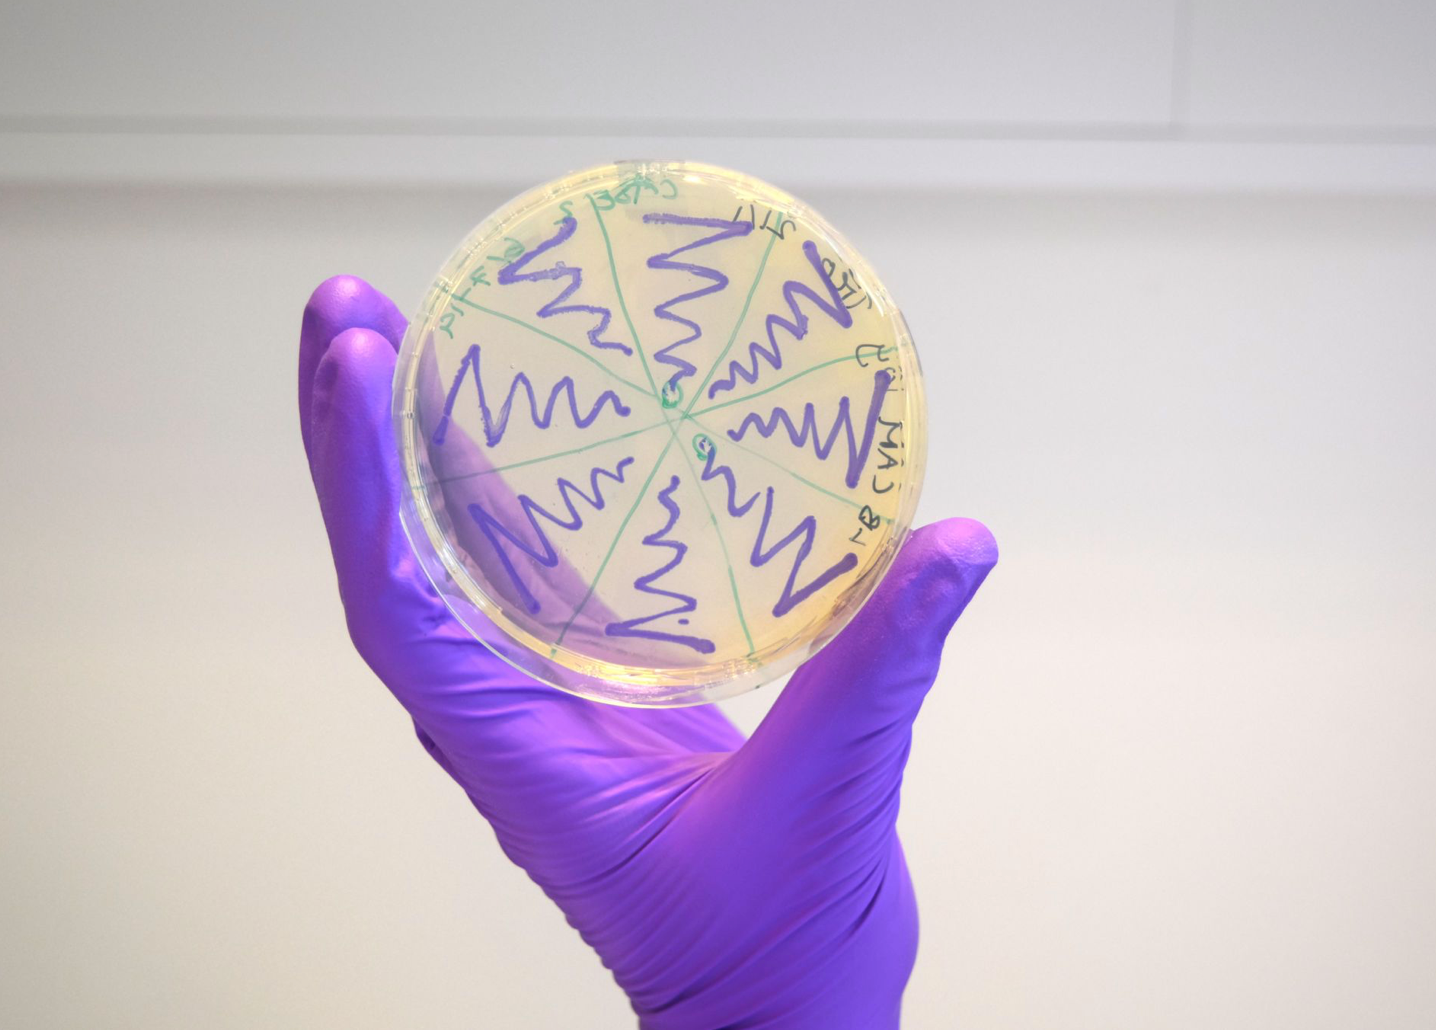

Hvorfor er det sejt?
Hurtige, troværdige og billige målinger af kemiske stoffers tilstedeværelse er et voksende behov indenfor flere industrier. Derfor er biosensorer blevet meget populære igennem de seneste år. En biosensor er en målemetode, hvor den aktive del, som måler er et biologisk element, som et antistof eller en bakteriecelle. Biosensorer har fundet anvendelse i mange felter: sundhedsvæsnet/medicinalindustrien, landbrug, miljøovervågning samt til sikkerhed og forsvar. Brugen af biosensorer som alkometer, covid-19 kviktest eller til måling af blodsukker, har vist sig at være effektive. Du kan også læse om en ny sej biosensor der kan måle PFAS her.
De er interessante, fordi de ofte er billigere og nemmere at benytte ned andre måleredskaber. Med Biotech Academys Biosensor case 2 øvelse, kan du få muligheden for at genmodificere E. coli bakterier til at fungere som en biosensor. Du skal indsætte genet for et farvet protein, som kun udtrykkes når acetylsalicylsyre er tilstede (Acetylsalicylsyre er den aktive ingrediens i Treo tabletter). Ved succesfuld transformation (indsættelse af genet som koder for et protein) kan du bruge dine bakterier til at afsløre tilstedeværelsen af acetylsalicylsyre,
Efter transformation af E. coli med AmilCP indeholdende plasmid, kan man som billedet viser renstryge kolonierne på ampilicin indeholdende agar petriskåle. Succesfulde transformanter giver blålilla flouroscens.
Hvad går øvelsen ud på?
Igennem biosensor case 2 forsøget får du mulighed for at opsætte og udføre et molekylærbiologisk forsøg. Case 2 gør brug af det blålilla fluorescerende protein AmilCP. Fluorescens betyder at proteinet optager fotoner ved en bølgelængde og udsender dem igen, ved en længere bølgelængde. Derfor vil proteinet “lyse af sig selv” efter at det er blevet belyst. Man kan dog godt se farven på proteinet med det blotte øje ved normalt lys.
Det farvede protein reguleres af transkriptionsfaktoren NahR. NahR bliver først aktiv ved tilstedeværelse af acetylsalicylsyre. Dette betyder at de genmodificerede E. coli celler vil blive blålilla, hvis vækstmediet indeholder Treo. Dette skyldes at NahR aktiveres af acetylsalicylsyre og udtrykket det farvede protein. Vi vurderer at forsøget tager 2-3 dage at udføre, og det er vigtigt at din lærer har fået laboratoriet godkendt til genmodificering. Vi anbefaler at du udarbejder dette forsøg i samarbejde med din lærer. På biosensors hjemmeside kan du lære mere om selve case 2 forsøget, og få en dybere forståelse af hvad det vil sige at genmodificere.
Hvilke metoder kommer du til at bruge?
- Transformation – heat shock
- Steril teknik – renstrygning
- Molekylærbiologisk forsøgsopsætning (Control forsøg, fortynding og selektionsmarkør)
- Vækstmedie produktion
- Aflæsning af bakterievækst på en plade
- Forsøgsdesign (kan man variere mængden af acetylsalicylsyre eller måle på andre typer prøver som blod)
Faglige vinkler og tværfaglige ideer
Bioteknologi – stofdetektion:
I et projekt om en acetylsalicylsyre biosensor kan man drage paralleller til mange forskellige fag. Eksempelvis har man målt udskillelse af acetylsalicylsyre efter indtagelse i forskellige patientgrupper, og fundet ud af at køn, gener/etnicitet og kost kan påvirke optagelsen af acetylsalicylsyre[1]. Det er interessant, da der er et stigende fokus på at medicin påvirker forskellige befolkningsgrupper forskelligt.
Case 2 forsøget kan også bruges som udgangspunkt i en tværfaglig undersøgelse af fordele og ulemperne bag genmodifcering og biosensorer i et moderne samfund. Her kan man lave en undersøgelse af om biosensorer er smarte med hensyn til etik og pris. Er biosensorer billigere? Er de bedre en andre stofdetektions metoder? Hvilke stoffer kan potentielt detekteres?
- Historie
- Hvornår blev genmodificering introduceret? Hvilken betydning har det haft for det moderne samfund? Hvilke biosensorer har været brugt historisk og hvordan har de påvirket verden?
- Dansk
- Lave en diskurs / argumentationanalyse af debatten omkring GMO.
- Matematik
- Hvordan måler man resultatet fra en biosensor? Hvordan konkludere man sikkert på signalet? Hvordan kender man forskel på signal og støj?
- Fysik
- Hvad er fluorescens? Hvordan bruges det til at visualisere i biologiske metoder?
- Samfundsfag
- Hvilke aktører findes der i GMO debatten? Hvad står de aktører for? Hvordan er lovgivningen om GMO, og hvordan har den ændret sig?
- Biologi/Kemi (bioteknologi)
- Hvilke typer af biosensorer findes der og hvad er deres molekylære virkningsmekanisme? Hvilke biosensorer er forslået i litteraturen og er de mulige at realisere?
- Filosofi / religion
- Undersøg begrebet “naturlighed” i forbindelse med GMO
Gode kilder til at komme i gang:
Forslag til litteratur, du kan bruge i din opgave og som baggrund for øvelsen:
Baggrundsviden
Litteratur:
- Sej ny biosensor, som kan måle PFAS https://biotech.auxodev3.dk/undervisning/gymnasiale-projekter/moderne-genteknologi/syntetisk-biologi/igem-2023/
- Miljøovervågning og sprængstofs detektion
https://biosensor.dk/biosensorer-i-den-virkelige-verden/ - Kræft detektion
https://www.ncbi.nlm.nih.gov/pmc/articles/PMC7262998/ - Videnskabelig artikel om biosensorer
https://www.ncbi.nlm.nih.gov/pmc/articles/PMC4862100/ - [1] https://www.ncbi.nlm.nih.gov/pmc/articles/PMC3121547/
Hjælp til metoder:
- Pipetering: https://biotech.auxodev3.dk/e-learning/film/laboratorieteknikker/#1516015617378-f54a407d-2722
- Sterilteknik: https://biotech.auxodev3.dk/e-learning/film/laboratorieteknikker/#1653580039862-a95e8546-5951
- Renstrygning: https://biotech.auxodev3.dk/e-learning/film/laboratorieteknikker/#1653580039203-210eebe6-6861
- Heat shock:https://www.youtube.com/watch?v=w_fZmiIAdco&t=89s
- (spørg lære for hjælp) LB til inokulation: https://www.youtube.com/watch?v=MxhxhMS5QiA
- (spørg lære for hjælp) LB til agar plader: https://www.youtube.com/watch?v=_MWv6hPUBQM
Husk:
Hvis du har nogle spørgsmål afholder vi et live event, hvor du kan stille alle dine spørgsmål til os d. 8 december 2025 fra 16-18:30 på dette link: https://discord.com/invite/7hq4MXxP.

